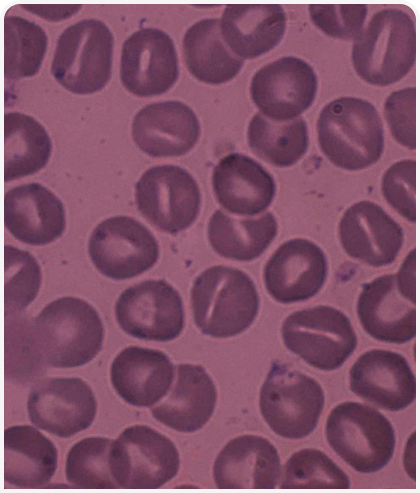

Введение
Анемия – один из самых распространенных клинических синдромов у домашних животных. Он часто выявляется при лабораторных анализах крови. Хотя в большинстве случаев причинами являются приобретенные состояния (инфекции, иммунные нарушения, интоксикация, кровопотеря и хроническая органная недостаточность), в клинической практике также необходимо учитывать наследственные дефекты эритроцитов. У домашних животных было обнаружено несколько вариантов таких дефектов.
В настоящее время имеется гораздо больше новой информации, в том числе о молекулярной базе некоторых нарушений. Это позволяет ставить более точные специфические клинические диагнозы (1, 2). Несмотря на то, что такие патологии у некоторых пород относительно часто встречаются и хорошо известны, нередко их рассматривают как причину лишь после безуспешного лечения иммунных и инфекционных заболеваний, а также в случаях особо долговременной или рецидивирующей анемии. В этом кратком обзоре основное внимание уделяется особенностям эритроцитов и ключевым аспектам клинической диагностики и тактике ведения собак и кошек с наследственными нарушениями функции красных кровяных телец.
Эритроциты собак и кошек
Хотя основные структурные особенности и функции эритроцитов у всех млекопитающих похожи, у собак и кошек между ними есть некоторые заметные различия. Эти клетки у кошек намного меньше, чем у собак. Поэтому нарушение их формы (образование сфероцитов) у кошек не распознается. Однако концентрации эритроцитарного гемоглобина (средняя концентрация гемоглобина в эритроцитах, MCHC) у обоих видов одинаковы.
Что интересно — существует несколько вариантов нормы. Например, у многих акита-ину наблюдается микроцитоз, тогда как у карликовых пуделей наблюдается, наоборот, макроцитоз. Нормальная продолжительность жизни красных кровяных телец одинакова у собак и людей (100–120 дней), однако у кошек этот срок составляет только 70–75 дней.
Красные кровяные тельца лишены ядра и митохондрий. Поэтому их метаболизм отличается ограниченностью и специфичностью. Его особенности позволяют таким клеткам сохраняться в кровяном русле и переносить кислород. Энергия, обеспечивающая внутриклеточные процессы в них, вырабатывается почти исключительно путем анаэробного гликолиза (путь Эмбдена-Мейергофа).
Гексозомонофосфатный шунт обеспечивает восстановление пиридиновых нуклеотидов и глутатиона, необходимых для расщепления окислителей, тем самым предотвращая повреждение мембраны и денатурацию гемоглобина вследствие окисления. Кроме того, система метгемоглобина или цитохром-b5-редуктазы восстанавливает железо из формы Fe3+ до формы Fe2+. Только восстановленный гемоглобин может связывать и переносить кислород. В цикле Рапопорта-Люберинга синтезируется 2,3-дифосфоглицерат (ДФГ), который влияет на сродство гемоглобина к кислороду у собак, но не у кошек. Действительно, концентрация ДФГ в эритроцитах у собак и людей сопоставима, однако у кошек намного ниже.
По всей видимости, у домашних животных имеется эмбриональный (HbE) гемоглобин, однако отсутствует фетальный (HbF). У собак обнаруживается только один тип зрелого гемоглобина, за исключением некоторых японских пород, у которых присутствуют два типа (HbA и HbB). Однако для выяснения всех свойств гемоглобина необходимы дальнейшие исследования. Интересно, что у кошек есть один α-глобин и по крайней мере шесть разных β-глобинов. У каждой кошки может быть от одного до четырех разных β-глобинов, вследствие этого возможно множество разных сочетаний.
Мембрана эритроцитов состоит из бислоя (двойного молекулярного слоя) липидов, прикрепленного к мембранному каркасу. Липидный слой задает дисковидную форму клетки и обеспечивает ее легкую деформируемость при прохождении через капилляры. Разные виды трансмембранных гликопротеинов выполняют функцию рецепторов или транспортеров. Эритроциты собак и кошек (за исключением некоторых японских пород) утрачивают Na+, K+-АТФазу во время позднего созревания в костном мозге вследствие протеолиза. Поэтому высокие концентрации натрия и низкие калия в эритроцитах аналогичны концентрациям этих электролитов в сыворотке крови. Вследствие этого гиперкалиемия после внутрисосудистого гемолиза или при хранении свернувшейся цельной крови обычно не наблюдается, за исключением случаев лизиса «стрессовых» (незрелых) ретикулоцитов или эритроцитов от японских пород с высоким содержанием калия.
Фактически эритроциты акита-ину в условиях in vitro (в пробирке) «негерметичны», поэтому в образцах сыворотки, которые не были немедленно отделены от сгустка, может наблюдаться псевдогиперкалиемия, которая не имеет клинической значимости (Вставка 1). Наконец, эритроциты собак отличаются исключительно коротким сроком жизни в щелочной среде, в отличие от клеток кошек и других видов. По-видимому, это происходит из-за более легкого поступления кальция в клетку в этих условиях. Эта чувствительность к pH может объяснить склонность эритроцитов собак к лизису при нахождении в незакрытых пробирках в лаборатории, а также она может лежать в основе гемолитических кризов, наблюдаемых у питомцев с дефицитом фосфофруктокиназы.

Группы крови
Мембраны эритроцитов также содержат несколько антигенов, определяющих группу крови. В настоящее время применяются разные наборы для определения группы в клинике и в лабораторных условиях (3). У собак, у которых отсутствует тот или иной антиген группы крови, могут вырабатываться аллогенные антитела после сенсибилизации вследствие переливания крови, что может быть причиной острых трансфузионных гемолитических реакций. У собак существует более двенадцати групп крови, из которых наибольшую клиническую значимость имеют группы крови DEA 1. Собаки могут иметь либо DEA 1-, либо от слабой до сильной DEA 1+.
Для переливания крови лучше использовать доноров DEA 1-, поскольку их кровь не вызывает сенсибилизации у реципиентов с DEA 1-. Кровь от доноров DEA 1+ можно переливать реципиентам с DEA 1+. Существуют и другие группы крови, имеющие клиническое значение, например, DEA 4 (99,9% собак имеют группу DEA 4+) и Dal (у далматинцев, а также у доберман-пинчеров, ши-тцу и лхасских апсо может быть Dal 4-) (4–6). Рекомендуется проводить типирование всех реципиентов и доноров по DEA 1. Если нужно больше одного переливания крови — через четыре дня после первой процедуры провести у всех пациентов перекрестную пробу на совместимость. Хотя для DEA 1 выявлен генетический маркер, в настоящее время ДНК-тестов для определения группы не существует.
Для кошек характерна система групп крови AB, с типами A, B и AB. Она довольно хорошо изучена, так как связана с встречающимися в природе аллоантителами, острыми трасфузионными гемолитическими реакциями и гемолитической болезнью новорожденных (у котят типов A и AB, рожденных от кошки типа B) без предварительной сенсибилизации. Поэтому всем реципиентам и донорам (а также кошкам, планируемым в разведение) необходимо определение группы крови.
Тип B и AB необходимо подтверждать повторным определением и обратным методом (для подтверждения присутствия сильных анти-А антител в плазме/сыворотке кошек старше 3 месяцев, относящихся к любому из типов В). Кроме того, в настоящее время у кошек обнаружены и другие группы крови. Последняя из обнаруженных определяется эритроцитарным антигеном, получившим название Mik. Такие антигены могут вызывать выработку аллогенных антител, которые приводят к противоречивым результатам перекрестной пробы на совместимость крови, а также к возникновению острых гемолитических трансфузионных реакций без предварительной сенсибилизации. Поэтому было бы разумно перед переливанием крови проводить кошкам перекрестную пробу на совместимость групп, а также определять группу по системе АВ. Тип AB встречается относительно редко, однако он часто наблюдается у породы рэгдолл. Недавно были разработаны ДНК-тесты для дифференциации типов A, B и AB
Классификация дефектов эритроцитов
Наследственные дефекты красных кровяных телец образуют большую и клинически гетерогенную группу заболеваний. Все эти нарушения встречаются относительно редко, хотя у определенных пород часто есть недостаток некоторых ферментов (Таблица 1). Все такие патологии у кошек наследуются аутосомно-рецессивным способом. Исключение — порфирия кошек и сфероцитоз, которые могут наследоваться как доминантный или рецессивный признак. Хотя характеристики этих заболеваний неодинаковы, многие из них, по-видимому, гомологичны наследственным заболеваниям у людей. Есть четыре группы нарушений функций эритроцитов у кошек:
· дефекты гема и гемоглобинопатии;
· нарушения структуры мембраны;
· дефициты гликолитических ферментов;
· нарушения процессов формирования и созревания клеток.
Несколько примеров таких заболеваний более подробно рассматриваются ниже. Обычно дефекты эритроцитов приводят к гемолитической анемии, которая характерна для всех групп патологий, за исключением нарушений процессов образования и созревания эритроцитов.

Хотя клинические признаки, тип и тяжесть анемии, а также наблюдаемые плейотропные эффекты могут служить ключом к определению конкретного наследственного дефекта эритроцитов (Таблица 2), для подтверждения диагноза или выявления новых наследственных нарушений необходимо проведение полной лабораторной оценки.
У нескольких пород выявлено больше одного такого дефекта. Для выявления гематологических нарушений и исключения приобретенных анемий используются штатные лабораторные анализы крови, включая полный анализ крови с подсчетом ретикулоцитов и микроскопическим анализом мазка крови, а также биохимический анализ сыворотки и анализ мочи.
У пациентов с отрицательной пробой Кумбса при гемолитической анемии, развившейся в отсутствие контакта с токсинами или инфекцией, и при нормальной функции печени и почек, имеет смысл заподозрить вероятность наследственных дефектов красных кровяных телец (7).
Тщательное изучение мазков периферической крови имеет значение при распознавании любого пойкилоцитоза (эллипсоцитоз, сфероцитоз и стоматоцитоз). Однако большинство дефектов не приводят к изменению формы клеток. Такие патологии традиционно называются несфероцитарными гемолитическими анемиями. Ретикулоцитоз некоторой степени часто отмечается даже при легкой анемии. Как правило, его выраженность пропорциональна снижению выживаемости дефектных клеток. Таким образом, исследование костного мозга редко дает новую информацию при дефектах красных кровяных телец.
Признаки гемолиза могут быть слабовыраженными вследствие хронической формы, сильных компенсаторных механизмов и малой степени гемолиза. Пациенты с такими патологиями могут очень хорошо адаптироваться к хронической анемии, и в этом случае общее состояние организма будет удовлетворительным. Обычно отмечаются гипербилирубинурия и гипербилирубинемия, однако они тоже могут быть слабовыраженными из-за адаптации к заболеванию. Также имеются данные о низком уровне гаптоглобина в сыворотке, гемоглобинемии или гемоглобинурии, указывающих на внутрисосудистый гемолиз. Однако такие результаты необходимо тщательно оценивать, так как они могут быть артефактами исследования.
Некоторые дефектные клетки крови в условиях in vitro погибают очень быстро, что приводит к их искусственному лизису в пробирках. У животных с метгемоглобинемией наблюдается цианоз (даже при дополнительной подаче кислорода). Также у них может развиваться вторичный эритроцитоз. Кроме того, у кошек с порфирией наблюдаются эритродонтия и пигментурия вследствие накопления порфирина.

Специальные лабораторные анализы для определения характера внутреннего дефекта эритроцитов можно разделить на общие скрининговые тесты, используемые для определения характера неизвестных нарушений функции клеток, и специфические скрининговые тесты для определения известных дефектов у конкретных пород. Обе разновидности тестов выполняются только в специализированных лабораториях. Также разработано несколько групп ДНК-тестов для конкретных пород собак, которые выявляют большинство описанных на данный момент дефектов ДНК*.
Гемолиз, вызванный дефектами эритроцитов, может быть хорошо скомпенсирован повышенным эритропоэзом. При этом не развивается никаких клинических признаков либо развиваются минимальные (за исключением кризов), что позволяет пациентам иметь нормальную продолжительность жизни и удовлетворительное общее состояние организма. Кроме того, животные с такими патологиями могут хорошо адаптироваться. Напротив, некоторые дефекты проявляются тяжелыми гемолитическими кризами, при которых может требоваться поддерживающее лечение, в том числе переливания крови.
При переливаниях необходимо проводить определение группы крови, а если они выполнялись ранее — перекрестные тесты на совместимость. У кошек с некоторыми дефектами эритроцитов развивается выраженная спленомегалия. В таких случаях иногда помогает спленэктомия, при которой удаляется основной участок разрушения эритроцитов. Судя по всему, собакам эта операция не помогает. Наконец, животные с такими дефектами не должны включаться в разведение, чтобы предотвратить дальнейшее распространение этих заболеваний. Однако в целях сохранения разнообразия генофонда бессимптомных носителей с желательными качествами можно безопасно скрещивать с животными, у которых этот дефект отсутствует, при условии, что все потомство, предполагаемое к разведению, также проходит скрининг с помощью ДНК-тестов, специфичных для этой мутации.
Дефекты гемоглобина
В отличие от распространенных случаев талассемии и серповидноклеточной анемии у людей, гемоглобинопатии у собак и кошек не зарегистрированы. У разных пород собак и у домашних короткошерстных кошек выявляют единичные случаи метгемоглобинемии, связанные с дефицитом цитохром-b5-редуктазы. Можно предположить наследственную или врожденную метгемоглобинемию, если капля крови на фильтровальной бумаге остается темной.
Следует учитывать, что наследственные метгемоглобинопатии часто сопровождаются цианозом и вторичным эритроцитозом, нежели анемией, однако при них существует риск массивного гемолиза вследствие воздействия окислительных агентов. К ним относятся некоторые лекарственные препараты, тяжелые металлы, лук или чеснок. У пораженных животных идентифицируются мутации в гене метгемоглобин-цитохром-b5-редуктазы (8).
Порфирии представляют собой группу врожденных патологий, возникающих в результате накопления в организме порфиринов из-за недостаточной активности специфических ферментов, участвующих в биосинтезе гема. В настоящее время они обнаружены у кошек. У людей эта группа заболеваний клинически определяется как эритроидная, с вовлечением кожи или печени, с острыми нейровисцеральными проявлениями. У кошек, страдающих порфирией, наблюдается эритродонтия (коричневые обесцвеченные зубы, которые флуоресцируют розовым цветом), порфиринурия и слабовыраженные гемолитические нарушения, однако никаких острых жизнеугрожающих нейровисцеральных проявлений или кожных патологий. Продолжительность жизни пациентов с порфирией близка к нормальной (9). Концентрация порфирина в моче у кошек с порфирией повышается. По содержанию порфирина в моче и дефициту фермента можно выделить острую перемежающуюся порфирию (ОПП, доминантная) или врожденную эритропоэтическую порфирию (ВЭП, рецессивная).
В гене гидроксиметилбилансинтазы (ГМБС, HMBS) или уропорфириноген-III-синтазы (УПГС, UROS) были обнаружены несколько мутаций, в том числе дупликации, делеции и миссенс-мутации, что делает его геном с наибольшей частотой мутаций из всех обнаруженных в настоящее время у кошек. Таким образом, у кошек с обесцвеченными зубами и нормальным состоянием крови либо легким гемолизом возможна недостаточная активность ГМБС или УПГС. Биохимические и молекулярные исследования упрощают скрининг поражённых кошек в специализированных лабораториях*.
Дефекты мембраны
Эллипсоцитоз и сфероцитоз, возникающие в результате дефицита белковой зоны 4.1 и спектрина цитоскелета, описаны на клиническом и молекулярном уровне у беспородных собак. В число других предполагаемых нарушений структуры мембраны входят стоматоцитоз у аляскинских маламутов, цвергшнауцеров и миттельшнауцеров, сфероцитоз у голден-ретриверов с гастритом, несфероцитарная анемия у биглей и повышенная осмотическая хрупкость эритроцитов у абиссинских и других чистопородных и беспородных домашних кошек. За исключением повышенной осмотической хрупкости у кошек, эти дефекты мембраны встречаются редко и в единичных случаях (Рисунок 1) (10).
Предполагается, что повышенная осмотическая хрупкость вызывается дефектом мембраны и/или системы транспорта ионов. Аляскинские маламуты с хондродисплазией и задержкой в развитии со стомацитозом были первыми собаками, у которых была описана хрупкость эритроцитов (11), однако точный стоматоцитозом не было обнаружено аномалий мембранного скелета. Интересно, что при тяжелом макроцитозе измерения, основанные на содержании гемоглобина, показывают лишь легкую анемию (12) (Рисунок 2).
Заметная повышенная осмотическая хрупкость в сочетании с перемежающейся анемией, тяжелой спленомегалией и гиперглобулинемией наблюдается у абиссинских кошек, а также у других чистопородных кошек и метисов. Эти клетки отличаются макроцитарностью, а также чрезвычайно короткой продолжительностью жизни in vitro. Они могут подвергаться лизису при обычном хранении в холодильнике. Хотя причина этого до сих пор не выяснена, есть предположения, что она заключается в дефекте мембраны. Кошкам с этой патологией и выраженной спленомегалией могут помогать противовоспалительные дозы преднизолона. При тяжелой, часто рецидивирующей анемии, сопровождающейся тяжелой спленомегалией, может потребоваться спленэктомия. Важно, что у пациентов с удаленной селезенкой очень часто в течение первого месяца после операции развивается сепсис. Некоторые лаборатории* предлагают тестирование осмотической хрупкости клеток.

«
«Наследственные дефекты эритроцитов представляют собой большую и клинически гетерогенную группу заболеваний, и в то же время удивительно, что некоторые отдельные нарушения встречаются относительно часто у определенных пород».
Энзимопатии эритроцитов
Недостаточность фосфофруктокиназы (ФФК) и пируваткиназы (ПК), двух ключевых регуляторных гликолитических ферментов, ведет к формированию двух отчетливо различимых разновидностей гемолитической анемии у нескольких пород собак, тогда как у многих пород кошек встречается перемежающаяся анемия, вызываемая только недостаточностью пируваткиназы (ПК) (Таблица 3).
Хотя недостаточность ПК была впервые описана у басенджи около пятидесяти лет назад, типичные клинические признаки и биохимические аномалии у других пород выглядят примерно так же и характерны только для собак. Напротив, у кошек с недостаточностью ПК наблюдается перемежающаяся анемия, симптомы которой больше похожи на симптомы недостаточности ФФК у собак. Многих пациентов до постановки диагноза ветеринарные врачи в течение нескольких месяцев или лет лечат от предполагаемой иммуноопосредованной гемолитической анемии. Тем самым животные подвергаются ненужным диагностическим вмешательствам и потенциально опасным методам лечения.

Недостаточность фосфофруктокиназы (ФФК)
Несмотря на то, что эта патология была обнаружена более трех десятилетий назад, а также несмотря на доступность ферментативных и ДНК скрининг-тестов, эта недостаточность гликолитических ферментов по-прежнему наблюдается у рабочих английских спрингер-спаниелей в США и Европе, а также встречается у некоторых выставочных линий собак, в том числе у кокер-спаниелей, уиппетов, вахтельхундов и собак-метисов. Недостаточность ФФК вызывается одной миссенс-мутацией в гене ФФК мышечной ткани, что приводит к усечению и нестабильности белковой цепочки фермента ФФК у всех перечисленных выше пород (за исключением вахтельхундов, у которых эта патология вызывается другой мутацией в гене ФФК (13)).
Это заболевание проявляется гемолитическими кризами и миопатией при повышенных физических нагрузках. Главным диагностическим признаком является спорадическая темная пигментурия, возникающая вследствие тяжелой гемоглобинурии и гипербилирубинурии, обычно после эпизодов чрезмерной гипервентиляции или лая, интенсивных физических нагрузок, а также повышения температуры или перегрева вследствие высокой окружающей температуры. Индуцированный гипервентиляцией алкалоз приводит к внутрисосудистому лизису эритроцитов с недостаточностью ФФК. Во время криза у больной собаки может наблюдаться сильная анемия и желтуха (Рисунок 3), а также повышение температуры, вялость и отсутствие аппетита, обычно проходящие в течение нескольких дней. В периоды между кризами у собаки наблюдается сильный регенеративный эритроидный ответ. Кроме того, у больных собак полностью отсутствует активность ФФК в мышцах, поэтому у них наблюдается метаболическая миопатия, характеризующаяся непереносимостью повышенных физических нагрузок, периодическими мышечными судорогами и умеренно повышенной активностью сывороточной креатинкиназы. Поскольку такие собаки не могут быстро бегать в течение длительного времени, они плохо подходят для использования в качестве служебных собак.

Для точной диагностики собак с недостаточностью ФФК и собак-носителей этого гена многими лабораториями предлагаются простые тесты, специфичные к этой мутации*. У пород, для которых не подтверждена мутация ФФК, показателем ее наличия может оказаться низкая активность фермента и/или высокая кривая диссоциации оксигемоглобина при проведении соответствующего анализа. Следует избегать ситуаций, которые могут стать инициирующим фактором (триггером) гемолитического криза – чрезмерной гипервентиляции, лая, повышенной физической нагрузки и перегрева.
Если у собаки случился криз, ей обычно необходим только покой, однако в некоторых случаях животным с этой патологией может потребоваться поддерживающее лечение, в том числе переливание крови. У собак с недостаточностью ФФК может быть нормальная продолжительность жизни, однако, несмотря на почти нормальный гематокрит, у них сохраняется стойкая гипербилирубинурия и ретикулоцитоз из-за высокого сродства эритроцитов с недостаточностью ФФК к оксигемоглобину.
Недостаточность пируваткиназы (ПК)
Несмотря на тяжесть и устойчивость анемии у собак с недостаточностью ПК, клинические признаки, за исключением бледности, выражены слабо, однако гемолитические кризы при этой патологии возникают в любом возрасте и могут привести к смерти животного. Этот тип нарушений отличается высокой регенеративностью, а количество циркулирующих в кровяном русле ортохромных эритробластов (ядерные эритроциты) и ретикулоцитов может достигать 90 %. При этом типе анемии может развиться прогрессирующий миелофиброз неизвестной этиологии, а также остеосклероз костного мозга (Рисунок 4) и генерализованный гемосидероз/гемохроматоз с сопутствующей печеночной недостаточностью (14), ведущие к смерти животного – обычно в возрасте до 6 лет. В то же время, есть данные о некоторых вест-хайленд-уайт-терьерах, керн-терьерах и биглях с недостаточностью ПК, доживших до 10 лет.
Молекулярно-генетическая основа недостаточности ПК была установлена у басенджи, биглей, лабрадор-ретриверов, мопсов, керн-терьеров и вест-хайленд-уайт-терьеров (15, 16); для этих пород разработаны тесты на специфические мутации ДНК, однако для других пород они неприменимы*. Недостаточность ПК также регистрируется у карликовых пуделей, карликовых эскимосских собак, такс и чихуахуа. Есть вероятность, что ранее описанная несфероцитарная гемолитическая анемия и остеосклероз у пуделей также вызываются недостаточностью ПК (17).
Для этих пород требуется громоздкий тест ферментативной активности ПК с изоферментным анализом для определения недостаточности ПК. Ветеринарному врачу может быть сложно отличить носителей мутации и гомозиготных нормальных собак только по активности эритроцитарного фермента может быть сложно. Клинические признаки у собак с этой патологией выражены слабо – вероятно, из-за хронической адаптации к тяжелой анемии и высоких концентраций ДФГ в эритроцитах, обеспечивающих легкую доставку кислорода (низкое сродство гемоглобина к кислороду).
Гепатомегалия и спленомегалия могут быть результатом тяжелого внесосудистого гемолиза, экстрамедуллярного гемопоэза и гемосидероза/гемохроматоза. Хелаторы железа предлагаются в качестве метода лечения, однако их эффективность и безопасность еще не доказана, в то время как спленэктомия не доказала свою эффективность.
Экспериментально доказана эффективность трансплантации костного мозга собакам с недостаточностью обоих ферментов, однако из-за вероятного отсутствия крупного донора, совместимого по комплексу гистосовместимости с реципиентом, а также из-за необходимости тяжелой супрессии костного мозга, этот метод лечения не предлагается к внедрению ветеринарным врачам в клиническую практику.

Недостаточность ПК у кошек
У кошек недостаточность ПК вызывает чаще перемежающуюся, а не хроническую анемию, с регенеративным эритроидным ответом от легкого до умеренного; у кошек не развивается остеосклероз. У кошек с этой патологией могут развиваться отложения (билирубиновые камни в желчном пузыре), а также печеночная недостаточность и легкая спленомегалия. Судя по имеющимся данным, противовоспалительные дозы преднизолона, а также спленэктомия в тяжелых случаях, уменьшают клинические проявления перемежающейся анемии. Кошки с этой патологией могут прожить до 11 лет (3).
Активность эритроцитарной ПК сильно снижается, а экспрессия ПК M-типа отсутствует, что упрощает биохимическую диагностику. Исследования, проведенные в конце 1990-х, показали, что недостаточность ПК вызывается одним дефектом сплайсинга, в результате которого из цепи ДНК вырезаются 13 оснований (18). Это заболевание было зарегистрировано у абиссинских, сомалийских и нескольких других породистых кошек, а также у домашних короткошерстных кошек на разных континентах. В настоящее время многие лаборатории проводят скрининг ДНК на эту мутацию. Всем кошкам с устойчивой или рецидивирующей анемией неясной этиологии после исследования на интоксикационные, инфекционные и иммуноопосредованные причины необходимо провести тест на недостаточность ПК, так как это гораздо более вероятная причина нарушений.
Сниженный эритропоэз
Ранее описанные дефекты приводят к сокращению срока жизни эритроцитов, гемолизу и регенеративным анемиям. Когда речь идет о дефектах эритроцитов, нарушения образования и созревания эритроцитов обычно не включаются в их число. Эти патологии проявляются не только в виде нерегенеративной анемии, но также в виде изменений в других клетках, формирующихся в костном мозге.
Имеются данные о селективной мальабсорбции кобаламина (витамина B12), которую также называют синдромом Иммерслуда-Грасбека, который вызывается дефектом подвздошнокишечных кобаламин-специфичных рецепторов. Этот синдром встречается у нескольких пород собак (19, 20). У ризеншнауцеров и австралийских овчарок присутствуют мутации в гене AMN, а у биглей, бордер-колли и венгерских овчарок – мутации в гене CUBN. У носителей с этой патологией наблюдается отставание в росте и кахексия различной степени, неврологические симптомы, лейкопения, тромбоцитопения, анемия, низкий уровень кобаламина в сыворотке и метилмалоновая ацидурия. Однако прогноз после постановки диагноза достаточно положительный – собаки хорошо реагируют на парентеральное введение кобаламина каждые 2-4 недели.
У одного кокер-спаниеля и нескольких других собак наблюдалась тяжелая микроцитарно-гипохромная анемия с низким содержанием сывороточного железа и невосприимчивостью к пероральному дополнительному приему железа (21). Выяснилось, что эта железодефицитная анемия, резистентная к лечению препаратами железа (IRIDA), вызывается дефектом гена TMPRSS6 (матриптазы-2), который регулирует производство гепсидина в организме и в конечном счете регулирует всасывание и биодоступность железа.
Клиническая картина при дефектах эритроцитов может сильно различаться: от тяжелой анемии до отсутствия симптомов. Во многих случаях отказ от иммуносупрессивной терапии и избегание ситуаций, провоцирующих кризы, позволяет пациентам с этими патологиями сохранять хорошее качество жизни, а в некоторых случаях — и почти нормальную ее продолжительность
Литература
-
1.Slutsky J, Raj K, Yuhnke ST, et al. A web resource on DNA tests for canine and feline hereditary diseases. Vet J 2013;197:182-187.
-
2.Donnor J, Kaukonen M, Anderson H. Genetic panel screening of nearly 100 mutations reveals new insights into the breed distribution of risk variants for canine hereditary disorders. PloS One 2016;11(8):e0161005.
-
3.Giger U: Blood typing and crossmatching: Assuring blood compatibility. Kirk’s Current Vet Therapy 2014 (online edition) section IV, 260-265 www.kestrel.ws/erasmus/docs/Kirks_Current_Veterinary_Therapy_XIV.pdf
-
4.Polak K, Acierno MM, Raj K, et al. Dog erythrocyte antigen 1: mode of inheritance and initial characterization. Vet Clin Pathol 2015;44:369-379.
-
5.Goulet S, Giger U, Arsenault J, et al. Prevalence and mode of inheritance of the Dal blood group in dogs in North America. J Vet Intern Med 2017;31:751-758.
-
6.Euler CC, Mizukami K, Raj K, et al. Survey of two new (Kai 1 and Kai 2) and other blood groups in dogs of North America. J Vet Intern Med 2016;30:1642-1647.
-
7.Caviezel LL, Raj K, Giger U. Comparison of 4 direct Coombs’ test methods with polyclonal antiglobulins in anemic and non-anemic dogs for in-clinic or laboratory use. J Vet Intern Med 2014;28:583-591.
-
8.Jaffey JA, Harmon MR, Villani NA, et al. Long-term treatment with oral methylene blue in a dog with hereditary methemoglobinemia due to cytochrome b5 reductase deficiency. J Vet Intern Med 2017;31:1860-1865.
-
9.Clavero S, Ahuja Y, Bishop DF, et al. Diagnosis of feline acute intermittent porphyria presenting with erythrodontia requires metabolic and molecular analyses. Vet J 2013;198:720-722.
-
10.Tritschler C, Mizukami K, Raj K, et al. Increased erythrocytic osmotic fragility in anemic domestic shorthair and purebred cats. J Feline Med Surg 2016;18:462-470.
-
11.Fletch S Pinkerton P. An inherited anaemia associated with hereditary chondrodysplasia in the Alaskan malamute. Can Vet J 1972;13(11):270-271.
-
12.Bonfanti U1, Comazzi S, Paltrinieri S, et al. Stomatocytosis in 7 related Standard Schnauzers. Vet Clin Pathol 2004;33(4):234-239.
-
13.Inal Gultekin G, Raj K, Lehman S, et al. Missense point mutation in PFKM associated with muscle-type phosphofructokinase deficiency in the Wachtelhund. Mol Cell Prob 2012;26:243-247.
-
14.Inal Gultekin G, Raj K, Foureman P, et al. Erythrocytic pyruvate kinase mutations causing hemolytic anemia, osteosclerosis and secondary hemochromatosis in dogs. J Vet Intern Med 2012;26:935-944.
-
15.Hlavac NRC, Lacerda LA, Conrado FO, et al. Hemolytic anemia caused by hereditary pyruvate kinase deficiency in the West Highland White Terrier dog. Arch Med Vet 2012;44:195-200.
-
16.Juvet F, Giger U, Battersby I, et al. Erythrocyte pyruvate kinase deficiency in three West Highland White Terriers in Ireland and the UK. Irish Vet J 2013;66;12 (epub).
-
17.Randolph JF, Center SA, Kallfelz FA, et al. Familial non-spherocytic hemolytic anemia in poodles. Am J Vet Res 1986;47(3):687-695.
-
18.Kushida K, Giger U, Inaba M, et al. Real-time PCR Genotyping assay for feline erythrocyte pyruvate kinase deficiency and mutant allele frequency in purebred cats in Japan. Vet Med Sci 2015;77:743-746.
-
19.Fyfe JC, Hemker LS, Venta JP. An exon 53 frameshift mutation in CUBN abrogates cubam function and causes Imerslund-Gräsbeck syndrome in dogs. Mol Gen Metabol 2013;109:390-396.
-
20.Fyfe JC, Hempkar SL, Stebbing B, et al. Selective intestinal cobalamin malabsorption with proteinuria (Imerslund-Gräsbeck syndrome) in juvenile beagles. J Vet Intern Med 2014;28:356-362.
-
21.Naigamwalla DZ, Webb J, Giger U. Iron deficiency anemia. Can Vet J 2012;53:250-256.



 1623
1623  25 мин
25 мин

 36
36 

